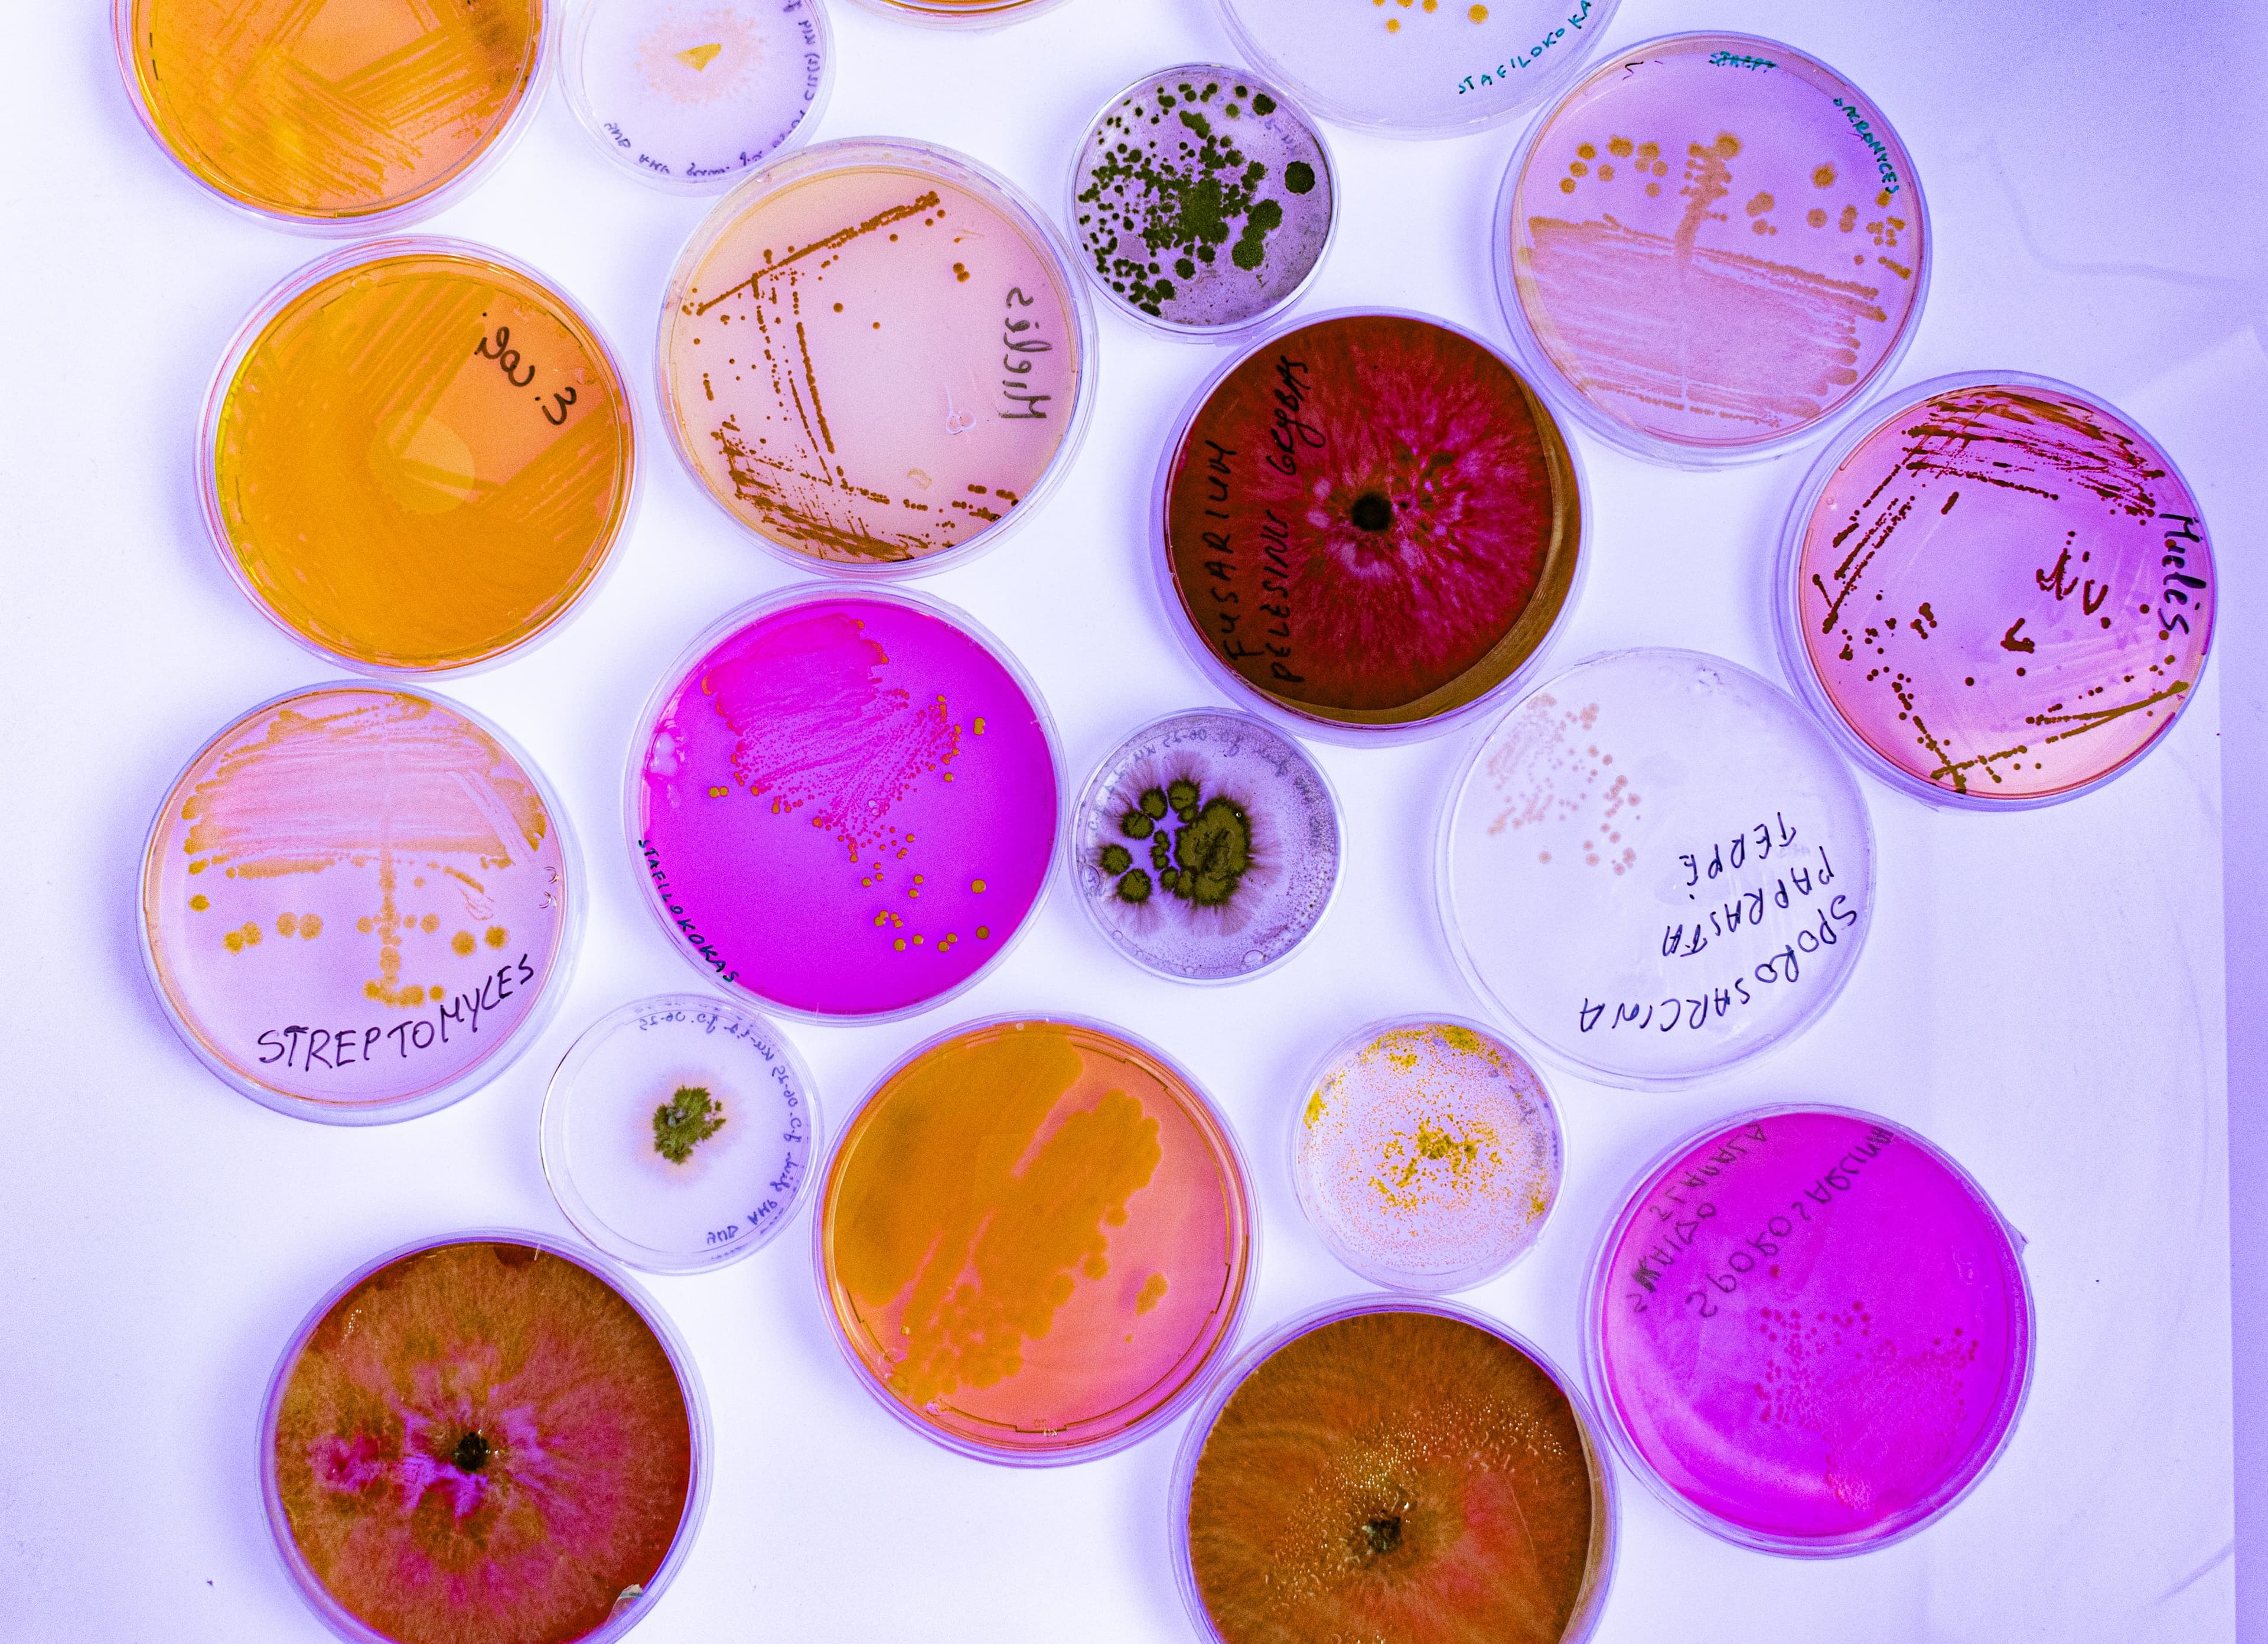
B_GMC_Mikrobiologija_II.jpg

Mikrobiologija
Mikrobiologija – mokslas, atskleidžiantis mikroorganizmų pasaulį ir jo reikšmę žmogui, pramonei bei aplinkai. Šiuolaikinės biotechnologijos neįsivaizduojamos be mikroorganizmų ar jų produktų naudojimo, o nauji metodai ir technologijos atveria naujas mikroorganizmų tyrimų ir pritaikymo sritis. Studijų metu nagrinėsite mikroorganizmų įvairovę, fiziologiją, biochemiją ir genetiką, mokysitės juos tirti bei praktiškai taikyti. Baigę studijas gebėsite kurti inovatyvius sprendimus ir profesionaliai taikyti mikrobiologijos žinias įvairiuose technologiniuose procesuose.
Mikrobiologijos studijos – tai kelias nuo gamtos ir tiksliųjų mokslų pagrindų iki taikomųjų mikroorganizmų tyrimų. Pradėsite nuo chemijos, matematikos, fizikos, biologinės įvairovės, ląstelės biologijos, genetikos ir molekulinės biologijos, kurios suteiks tvirtą teorinį pagrindą. Vėliau gilinsitės į mikrobiologiją, biotechnologiją, imunologiją, mikroorganizmų genetiką, bioinformatiką, maisto, pramoninę ir aplinkos mikrobiologiją bei patogeninius mikroorganizmus. Kursinis darbas, profesinė praktika laboratorijose ir bakalauro baigiamasis darbas leis realiai pritaikyti įgytas žinias.
Konkursinis balas
| Biologija | 0,4 | |
| Chemija arba matematika, arba informacinės technologijos, arba fizika | 0,2 | |
| Bet kuris dalykas, nesutampantis su kitais dalykais | 0,2 | |
| Lietuvių kalba ir literatūra | 0,2 |
Minimalieji reikalavimai
Minimalieji reikalavimai nurodo, ar gali dalyvauti konkurse į norimą studijų vietą. Šie reikalavimai priklauso nuo vidurinio išsilavinimo įgijimo metų.
Minimalieji reikalavimai vidurinį išsilavinimą įgijusiems 2026 m.:
- Išlaikyti ne mažiau kaip 3 valstybinius brandos egzaminus
- lietuvių kalbos ir literatūros bendruoju (B) arba išplėstiniu (A) kursu;
- matematikos bendruoju (B) arba išplėstiniu (A) kursu;
- stojančiojo laisvai pasirenkamą valstybinį brandos egzaminą.
- Egzaminų rezultatai turi būti ne mažesni nei pagrindinis pasiekimų lygmuo. Tai reiškia, kad trijų laikytų VBE įvertinimų aritmetinis vidurkis turi būti nuo 50 balų.
Jeigu vidurinį išsilavinimą įgijai anksčiau, pasitikrink reikalavimus pagal savo metus:
Papildomi balai
Papildomi balai pridedami prie tavo konkursinio balo stojant į universitetą. Papildomi balai gali padidinti tavo bendrą konkursinį balą ir sustiprinti galimybes patekti į norimą studijų programą.
Jie skiriami už pasiekimus, rodančius tavo aktyvumą, žinias ir iniciatyvą – pavyzdžiui, už olimpiadų ar konkursų prizines vietas, aukštą brandos darbo įvertinimą, savanorystę ar kitus reikšmingus pasiekimus.
Stojant į valstybės finansuojamas (VF), valstybės nefinansuojamas su stipendija (VNF/ST) ir valstybės nefinansuojamas (VNF) vietas, prie tavo konkursinio balo gali būti pridėta iki 2,5 papildomų balų.
1
2
3
4
- Tirti mikroorganizmus ir taikyti žinias praktikoje. Gebėsi atlikti tyrimus taikydamas (-a) šiuolaikinius mikrobiologijos ir biotechnologijos metodus, dirbti su standartine analitine ir mokslinių tyrimų įranga, planuoti, organizuoti ir vertinti eksperimentus lauko ir laboratorijos sąlygomis, laikantis geros laboratorinės praktikos, darbo saugos ir aseptinės technikos principų.
- Kritiškai mąstyti ir spręsti profesines problemas.
- Gebėsi vertinti skirtingus argumentus, susijusius su mikrobiologijos ir biotechnologijos klausimais, analizuoti žinomo ir nežinomo pobūdžio problemas, siūlyti sprendimo būdus ir taikyti mikrobiologijos žinias maisto, farmacijos, pramonės ar aplinkos apsaugos kontekste. Tobulėjimas profesinėje srityje.
- Gebėsi nuolat atnaujinti žinias, sekti mikrobiologijos ir biotechnologijų mokslo naujoves, reflektuoti savo profesinę veiklą ir kryptingai gilinti kompetencijas viso gyvenimo mokymosi kontekste.
- 4 201 EUR
Stipendijos
Vilniaus universiteto studentai gali pretenduoti į stipendijas už gerus studijų rezultatus, aktyvią mokslinę, sportinę ar visuomeninę veiklą, taip pat socialinę paramą studentams sudėtingose gyvenimo situacijose.
Valstybės remiamos paskolos
Studentai gali pasinaudoti valstybės remiamomis paskolomis, kurios suteikiamos pagal Lietuvos Respublikos Vyriausybės nustatytą tvarką. Šios paskolos skirtos padėti finansuoti studijas ir gyvenimo išlaidas studijų metu.
Galimi paskolų tipai:
- Paskola studijų kainai sumokėti – skirta padengti studijų įmokas.
- Paskola gyvenimo išlaidoms – skirta kasdienėms išlaidoms studijų laikotarpiu.
- Paskola dalinėms studijoms užsienyje – skirta studentams, išvykstantiems dalinėms studijoms pagal mainų programas.
Paskolų išdavimą, tarpininkaujant Universitetui, administruoja Valstybinis studijų fondas.
Studijų įmokos sumažinimas
Studijų įmoka gali būti sumažinta šiais atvejais:
- Aktyvi mokslinė veikla: Jei studentas aktyviai dalyvauja mokslinėje veikloje, įmokos sumažinimas gali būti nuo 30 proc. iki 100 proc., priklausomai nuo pasiekimų (pasaulio/Europos konkursų nugalėtojas/prizininkas, patentų bendraautorius, Lietuvos konkursų nugalėtojas/prizininkas).
- Aktyvi kultūrinė veikla: Jei studentas ne mažiau kaip 2 metus aktyviai dalyvauja universiteto kultūrinėje veikloje, įmokos sumažinimas gali būti nuo 30 proc. iki 90 proc., priklausomai nuo pasiekimų (Universiteto meno kolektyvo narys, prizinės vietos konkursuose).
- Aktyvus sportas: Jei studentas aktyviai sportuoja ir atstovauja Universitetui, įmokos sumažinimas gali būti nuo 30 proc. iki 100 proc., priklausomai nuo sportinių pasiekimų (Olimpinės rinktinės narys/kandidatas, pasaulio/Europos čempionatų nugalėtojas/prizininkas, SELL, Lietuvos čempionatai).
Universiteto darbuotojams: Universiteto darbuotojui gali būti sumažinta jo mokama studento ir (ar) klausytojo studijų įmoka iki 70 proc., jei jis dirba Universitete ne mažesne kaip pusės etato dalimi ir dirba Universitete bent 10 mėnesių nepertraukiamai.
Svarbu atkreipti dėmesį, kad kiekvienu atveju sumažinimo dydis ir sąlygos gali skirtis, o sprendimą dėl sumažinimo priima Universiteto kamieninio akademinio padalinio vadovas (arba, kai kuriais atvejais, Universiteto rektorius), atsižvelgdamas į konkrečias aplinkybes.
Studijų kainos kompensavimas
Tai galimybė studentams susigrąžinti dalį ar visą sumokėtą studijų kainą už aukštus akademinius rezultatus.

Karjeros galimybės
Ar šioje programoje galiu rinktis individualiųjų studijų galimybę?
Taip, nuo antrojo studijų semestro gali pasinaudoti individualiųjų studijų galimybe – pasirinkti dalį (nuo 10 iki 25 proc.) studijų dalykų, kurie bus integruoti į jūsų studijų programą. Daugiau informacijos rasite čia.